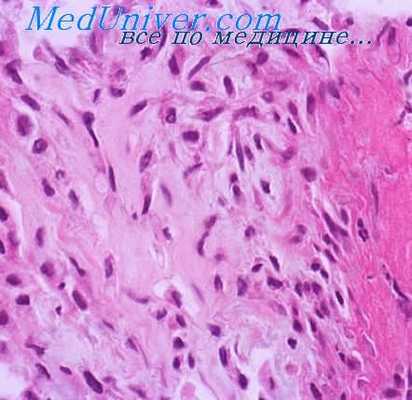
зернистоклеточная опухоль

Зернистоклеточная опухоль. Признаки и диагностика зернистоклеточной опухоли.
Добавил пользователь Дмитрий К. Обновлено: 30.01.2026
Злокачественная зернистоклеточная опухоль. Признаки злокачественной зернистоклеточной опухоли.
Злокачественная зернистоклеточная опухоль — очень редкая злокачественная опухоль, происходящая из шванновских клеток. Ее частота по отношению к доброкачественной зернистоклеточной опухоли составляет 1-3%. Возраст больных с впервые установленным диагнозом варьирует от 23 до 82 лет и в среднем составляет 48 лет. Таким образом, эта опухоль развивается почти на 10 лет позже, чем доброкачественная зернистоклеточная опухоль. Соотношение мужчин и женшин составляет 2,4:1, что сходно с доброкачественной опухолью.
Этиология злокачественной зернистоклеточной опухоли не ясна. Не исключена роль в ее развитии раздражающих факторов (острая пища, жевательный табак). Неизвестно, возникает ли злокачественная опухоль de novo или как результат злокачественной трансформации доброкачественной опухали. Ряд авторов отмечали, что у некоторых больных длительно существовавший узел внезапно начинал увеличиваться в размерах.
Клиническая картина злокачественной зернистоклеточной опухоли не имеет существенных особенностей. Обычно опухоль солитарная (реже множественная), представлена округлым плотным возвышающимся узлом белесоватого или коричневого цвета, диаметр которого варьирует от 1,5 до 4-10 см. Опухоль располагается в коже или под кожей и лишь иногда имеет ножку. Локализуется на любых участках тела, спинке языка или на слизистых оболочках. Описано несколько случаев ее внекожной локализации, включая мочевой пузырь и гортань. В большинстве случаев она безболезненна. Клиническими признаками, позволяющими заподозрить злокачественнкую, а не доброкачественную зернистоклеточную опухоль, являются больший размер, быстрый рост, инвазия соседних структур и изъязвление. Эти признаки могут помочь при трудностях различия этих опухолей на основании результатов гистологического исследования.
Течение злокачественной зернистоклеточной опухоли сопровождается медленным увеличением опухали в размере. Метастазирование отмечается довольно редко. Оно чаще лимфогенное, но может быть и гематогенным. Наиболее частые места метастазирования — регионарные лимфоузлы, легкие, печень и кости, реже опухоль метастазирует в селезенку, центральную нервную систему, молочную железу, сердце, перикард и поджелудочную железу. Также описаны широко распространенные метастазы в поперечнополосатые мышцы и кожу.
Макроскопически злокачественная зернистоклеточная опухоль обычно плохо отграничена и инфильтративна. В то же время поверхность ее среза по цвету и консистенции может напоминать доброкачественную зернистоклеточную опухоль.
Гистологически злокачественные зернистоклеточные опухоли могут выглядеть идентично своим доброкачественным аналогам, но в них обычно более выражен плео-морфизм, определяются увеличенные ядра с выступающими нуклеолями и большая популяция относительно мелких веретенообразных клеток. Митотическая активность, если она есть, может быть низкой: 2 митоза на 10 полей большого увеличения микроскопа. Однако и это должно настораживать врача в отношении возможности злокачественного процесса. Отмечаются некроз и сосудистая инвазия.
Диагноз злокачественной зернистоклеточной опухоли устанавливается на основании данных гистологического исследования. Для раннего выявления метастазов иногда используют метод ядерно-магнитного резонанса.
Ряд авторов для обозначения зернистоклеточных опухолей с гистологической атипией, ядерным плеоморфизмом, повышенным ядерно- цитоплазматическим соотношением, увеличенными нуклеолами и более агрессивным, чем при доброкачественных зернистоклеточных опухолях, течением предложили термин «ати пичная зернистоклеточная опухоль». Такие опухоли отличаются быстрым ростом и местными рецидивами, но не сопровождаются гематогенным метастазированием. Таким образом, они занимают промежуточное положение между доброкачественными зернистоклеточными опухолями и злокачественными. Разделение доброкачественных, атипичных и злокачественных зернистоклеточных опухолей, по мнению ряда авторов, следует проводить на основании использования 6 гистологических критериев. Злокачественные опухоли предложено выделять при обнаружении хотя бы 3 из 6 следующих признаков:
1) некроз;
2) наличие веретенообразных клеток;
3) повышенная митотическая активность;
4) увеличение размеров ядер;
5) наличие крупных нуклеол;
6) ядерный плеоморфизм.
До 63% больных злокачественными зернистоклеточными опухолями, диагноз которым был установлен в соответствии с этими критериями, имели персистирующее течение болезни, нередко с летальным исходом.
Ни гистохимическое, ни иммуногистохимическое окрашивание не помогает отличить злокачественные от доброкачественных зернистоклеточных опухолей. Клетки злокачественных и многих доброкачественных зернистоклеточных опухолей положительно окрашиваются на протеин S-100, виментин, нейронспе-цифическую энолазу, основной протеин миелина и другие протеины, ассоциируюшиеся с нервной тканью. Однако они не окрашиваются на мышечно-специфический актин, миозин, десмин и миоглобин, что облегчает дифференциальный диагноз зернистоклеточных опухолей с опухолями, гистогенетически связанными с мышцами.
Информация на сайте подлежит консультации лечащим врачом и не заменяет очной консультации с ним.
См. подробнее в пользовательском соглашении.
Зернисто-клеточная карцинома почки ( Гранулярно-клеточный рак почки )
Зернисто-клеточная карцинома почки – это гистологическая форма почечно-клеточного рака, развивающегося из паренхимы органа. Проявляется ренальными (гематурией, болью, пальпируемой опухолью) и экстраренальными (лихорадкой, слабостью, похуданием и др.) симптомами. Диагноз устанавливается на основе УЗИ почек, экскреторной урографии, ангиографии, МРТ, КТ, радиоизотопной сцинтиграфии. Лечение включает частичную или радикальную нефрэктомию, нередко – адреналэктомию, иммунотерапию; реже – гормонотерапию, химиотерапию или лучевую терапию.

Общие сведения
Зернисто-клеточная карцинома почки (гранулярно-клеточный рак) в клинической урологии встречается в 7-12% от всех случаев почечно-клеточного рака. Макроскопически неоплазии имеют коричневатый цвет, обусловленный скоплением фосфолипидных комплексов в многочисленных митохондриях, заполняющих раковые клетки. При микроскопическом исследовании опухоль представлена полигональными клетками с широкой зернистой цитоплазмой, различной степенью клеточной атипии и полиморфизма, обширными зонами кровоизлияний и некроза. Отличительной чертой новообразования является склонность к инвазии почечной вены.

Причины
Судить о причинах зернисто-клеточной формы карциномы почки не представляется возможным. В настоящее время выделены прогностические факторы потенциального риска, повышающие вероятность развития злокачественных опухолей в целом. Замечено, что пик заболеваемости отмечается в возрасте 50-70 лет, причем рак почки 2-3 раза чаще встречается у мужчин. Риск развития патологии выше у представителей негроидной расы.
Главным предрасполагающим фактором считается курение, повышающее вероятность возникновения рака почки в 2 раза. В числе других вероятных причин выделяют генетическую предрасположенность, некоторые наследственные заболевания, иммунодефицит, ожирение, воздействие ионизирующего излучения, нахождение пациента на длительном гемодиализе и др.
Классификация
Распространенность зернисто-клеточного рака почки оценивается по системе TMN:
- Т1 – карцинома расположена в центре почечной паренхимы, не пальпируется и выявляется исключительно рентгенологически.
- Т2 – определяется пальпируемая карцинома без признаков местноинвазивного роста.
- Т3 N1– карцинома прорастает в надпочечник, вены, или окружающие ткани либо имеется одиночный метастаз в регионарный лимфоузел.
- Т4 N1(N2) M0 (М1) – множественные метастазы в лимфоузлы, прорастание в соседние органы, наличие отдаленного метастазирования.
Метастазирование рака почки происходит по кровеносным и лимфатическим путям. Регионарные и отдаленные метастазы обнаруживаются более чем в половине случаев. Зонами регионарного метастазирования служат парааортальные и паракавальные лимфоузлы; отдаленными метастазами чаще поражаются легкие, кости таза, позвоночника, плечевого пояса, свода черепа, ребра. Местная инвазия наблюдается в паранефральную клетчатку, постоперационный рубец, мышцы и подкожную жировую клетчатку передней брюшной стенки.
Симптомы карциномы почки
Клиническая картина складывается из ренальных и экстраренальных проявлений. К ренальным симптомам относится классическая триада – наличие пальпируемой опухоли, гематурии и боли. Обычно присутствуют 1 или 2 симптома триады, но все они, как правило, уже свидетельствуют о распространенном опухолевом процессе. Гематурия при зернисто-клеточной карциноме почки наблюдается в 50-60% случаев, отличается высокой интенсивностью, развивается внезапно и часто не сопровождается болевым синдромом.
Острый болевой приступ может возникнуть после прекращения гематурии, при обтурации мочеточника кровяным сгустком. При неопухолевых поражения почек, протекающих с гематурией (гидронефрозе, мочекаменной болезни), боль, как правило, предшествует появлению крови в моче. В случае рака почки гематурия носит перемежающийся характер, при этом интервалы между кровотечениями постепенно укорачиваются. Боли в поясничной области встречаются почти у половины пациентов; пальпируемая опухоль – у 30-40%. Экстраренальная (внепочечная) симптоматика обычно включает беспричинную лихорадку, ухудшение самочувствия, потерю аппетита, слабость, анемию, похудание.
Осложнения
У 5-10% пациентов с бластоматозным процессом в почках развивается артериальная гипертензия. У мужчин важным симптомом карциномы служит развитие варикоцеле, которое может быть обусловлено сдавлением или опухолевой инвазией почечной вены, одной из яичковых вен либо тромбозом нижней полой вены.
Метастазы карциномы почки в легкие могут явиться случайно находкой при флюорографии или обнаружить себя кровохарканьем. Метастатическое поражение скелета протекает с интенсивными упорными болями, не купирующимися наркотическими средствами. При вовлечении трубчатых костей (бедренной, плечевой) могут развиваться патологические переломы; при заинтересованности позвоночника - параплегии, нарушения функций тазовых органов.
Диагностика
Визуально и пальпаторно могут быть обнаружены только запущенные формы рака почек. При осмотре врач-нефролог может обратить внимание на варикоцеле, отеки на нижних конечностей, расширение подкожных вен на передней брюшной стенке. Пальпация опухоли и степень ее подвижности позволяют судить о распространенности ракового процесса.
Из тестов лабораторной диагностики при обследовании используются общий анализ мочи (эритроцитурия, лейкоцитурия, протеинурия) и общий анализ крови (анемия, повышение СОЭ), биохимические исследования крови, однако все обнаруживаемые в них изменения являются неспецифичными. Патогномоничным признаком почечной карциномы служат изменения метаболизма сывороточных белков (трансферрина, ферритина, альбумина), выявляемые с помощью иммунодиффузного анализа.
Важным этапом онкоурологического обследования является УЗИ почек, посредством которого удается выявить деформацию контуров паренхимы, прорастание опухоли в сосуды, тромбоз вен, увеличенные регионарные лимфоузлы и т. д. Ультрасонография помогает дифференцировать карциному от гидронефроза, пионефроза, поликистоза почек, солитарной кисты почки.
Рентгенологическое обследование начинают с выполнения обзорной урографии, позволяющей судить об изменении конфигурации почки. В дальнейшем проводится экскреторная урография, дающая сведения о морфологическом и функциональном состоянии пораженной и здоровой почки. Для оценки заинтересованности почечных сосудов и степени васкуляризации опухоли прибегают к выполнению УЗДГ и почечной ангиографии; в случае подозрения на опухолевый тромб - нижней кавографии и почечной венографии.
С целью стадирования бластоматозного процесса используется магнитнорезонансная, компьютерная томография, нефросцинтиграфия. Биопсия почки ввиду опасности рассеивания опухоли применяется редко. С целью выявления отдаленного метастазирования показано проведение рентгенографии легких и костей, УЗИ органов брюшной полости.
Лечение карциномы почки
При выявлении операбельной зернисто-клеточной карциномы показана хирургическая тактика. Операция на почке проводится даже в случае обнаружения одиночного метастаза, поскольку позволяет продлить жизнь больному. При ранней диагностике карциномы возможно выполнение частичной нефрэктомии, однако чаще производится тотальная нефрэктомия, нередко с односторонней адреналэктомией и удалением регионарных лимфоузлов, извлечением опухолевых тромбов из почечной и нижней полой вен.
К назначению лучевой терапии, химиотерапии или гормонотерапии прибегают при неоперабельности почечного рака. Лучший прогностический результат достигается проведением иммунотерапии альфа-интерфероном, 5-фторурацилом, интерлейкином-2, которая позволяет повысить сроки выживаемости.
Прогноз и профилактика
Отдаленный прогноз во многом определяется стадией бластоматозного поражения. Течение зернисто-клеточной карциномы почки в большинстве случаев неблагоприятное; прогноз ухудшается при прорастании опухоли в почечную вену, наличии отдаленного метастазирования. Профилактика рака почек требует отказа от курения, исключения неблагоприятных химических и ионизирующих воздействий на организм.
Опухоль Абрикосова ( Зернисто-клеточная опухоль )
Опухоль Абрикосова – это зернисто-клеточное новообразование, которое поражает кожу, подкожную клетчатку и внутренние органы. Гистологическое происхождение и этиологические факторы заболевания пока точно не установлены. Доброкачественные варианты патологии имеют малосимптомное течение, опухоли поверхностной локализации проявляются в виде плотного безболезненного узла. Для диагностики патологии Абрикосова назначают микроскопический и иммуногистохимический анализ, инструментальные методы визуализации. Лечение предполагает хирургическое иссечение опухолевой ткани, в стандартных случаях медикаментозная терапия не применяется.
МКБ-10


Опухоль получила свое название в честь российского патологоанатома А.И. Абрикосова, который детально изучил особенности новообразования и в 1926 году выделил его в отдельную нозологическую единицу. Зернисто-клеточные опухоли (ЗКО) составляют до 10% среди всех доброкачественных новообразований. Они в основном диагностируются у пациентов 30-50 лет, женщины болеют 3 раза чаще мужчин. Актуальность проблемы в практической онкологии связана с частым рецидивированием новообразования после его удаления, риском злокачественной трансформации.
Природа развития опухоли Абрикосова пока точно не установлена. Ранее считалось, что новообразование возникает из миобластов – молодых веретеновидных мышечных клеток. По современным представлениям, патология имеет гистиоцитарное или нейрогенное происхождение. Источником для ее развития выступают шванновские клетки (леммоциты), которые входят в состав миелиновой оболочки периферических нервов.
Патанатомия
Несмотря на неясность этиопатогенеза, ЗКО имеют характерную микроскопическую структуру, которая облегчает диагностику. Объемное образование состоит из крупных многоугольных клеток, в цитоплазме которых расположены множественные включения. Клетки формируют отдельные гнезда, ленты и пучки. Клеточные ядра мелкие, имеют округлую форму и интенсивную окраску. Между зернистыми клетками располагаются «угловатые тельца» – гистиоциты треугольной формы.
Покрывающие ЗКО эпителиальные клетки также имеют особое микроскопическое строение. Эпителий подвергается метаплазии и псевдоэпителиоматозной гиперплазии. При беглом осмотре клеток под микроскопом создается картина плоскоклеточного рака кожи, однако отсутствие ядерной атипии и множественных митозов позволяет опровергнуть этот диагноз. Активную гиперплазию связывают с гиперэкспрессией эпидермального и трансформирующего факторов роста.

Согласно международной классификации заболеваний (МКБ-10), опухоль Абрикосова относят к доброкачественным новообразованиям рта и ротоглотки. Особое внимание врачей привлекают злокачественные виды ЗКО, которые составляют около 2% от всех случаев заболевания. Они в основном располагаются в мягких тканях нижних конечностей. По гистологическим признакам выделяют 2 варианта злокачественных опухолей:
- Первый тип. Злокачественные клетки не имеют резко выраженных признаков атипии, число митозов составляет не более 2 на 10 полей зрения. Присутствуют явные клинические симптомы инвазивного роста, такие как быстрое увеличение образования в размерах, изъязвление, кровотечение.
- Второй тип. Новообразование имеет явные признаки злокачественности и зачастую выявляется на этапе метастазирования. При иммунологической диагностике определяется большое число маркеров пролиферации Ki-67 и выраженная экспрессия р53.
Симптомы опухоли Абрикосова
Более 70% случаев локализованы в области головы и шеи, до 30% пациентов имеют ЗКО в толще языка. К менее типичным локализациям относят кожу и подкожную клетчатку на конечностях, область молочных желез у женщин. Изредка опухоль Абрикосова поражает внутренние органы, чаще всего дыхательную систему — гортань, трахею, бронхи, пищеварительную систему — пищевод и толстую кишку. До 10% случаев проявляются множественными узлами в коже и внутренних органах.
Доброкачественное образование в коже и подкожной клетчатке представлено узлом плотноэластической консистенции и не доставляет дискомфорта больному. При злокачественном течении кожной опухоли Абрикосова клинические симптомы более выражены. Пациенты замечают бляшку или узел на коже, который быстро увеличивается в размерах, покрывается язвами и кровоточит. Патология сопровождается болями, которые усиливаются при прикосновениях и надавливании на пораженную зону.
Клинические проявления связаны с расположением новообразования в определенном участке внутреннего органа. Симптоматика будет зависеть от размера ЗКО. При опухоли Абрикосова в органах дыхания пациенты жалуются на одышку, приступы удушья, сухой кашель. Нарушение вентиляции становится причиной частых и затяжных пневмоний. Поражение желудочно-кишечного тракта появляется болями в животе, задержкой стула, признаками кишечной непроходимости.
Доброкачественные варианты опухоли Абрикосова имеют благоприятное течение, при небольших и средних размерах они не нарушают работу организма. Вызывают опасения крупные новообразования, которые перекрывают просвет дыхательных путей или пищеварительного тракта, становятся причиной серьезных функциональных нарушений в организме. Несмотря на доброкачественный характер, после хирургического лечения зернисто-клеточная опухоль может рецидивировать.
Злокачественные ЗКО отличаются осложненным течением. Они многократно рецидивируют после удаления, вызывают множественные метастазы в течение первых 2-х лет от начала заболевания. Метастазы способны поражать все органы и ткани, нарушая их функции и затрудняя подбор эффективных методов терапии. Около 60% пациентов со злокачественными опухолями Абрикосова погибают в течение первых 3-х лет от онкологических осложнений.
За первичной консультацией пациенты обращаются к дерматологу, терапевту или пульмонологу, что зависит от локализации новообразования и клинических симптомов. Далее проводится расширенное обследование у врача-онколога, чтобы подтвердить диагноз ЗКО Абрикосова, исключить другие варианты злокачественных процессов. Диагностическая программа состоит из следующих методов:
- Инструментальная визуализация. При кожной локализации новообразования основную роль играет цифровая дерматоскопия. Для выявления опухоли во внутренних органах назначается рентгенография легких и ЖКТ, эндоскопические методы (бронхоскопия, ЭФГДС, колоноскопия). Для уточнения диагноза используют компьютерную и магнитно-резонансную томографию пораженной зоны тела.
- Электронная микроскопия. Ценную информацию для постановки диагноза дает выявление многоугольных клеток, «угловатых телец», типичных патологий эпителиального слоя. При опухоли Абрикосова в клетках визуализируются осмиофильные гранулы, которые содержат разрушенные клеточные фрагменты.
- Иммуногистохимическое исследование. Диагностика назначается для определения происхождения опухолевых клеток, идентификации ряда протеинов и нейроспецифических маркеров. Зачастую в клетках одновременно присутствуют признаки дифференцировки в гистиоцитарном и нейрогенном направлениях.
Дифференциальная диагностика
При постановке диагноза необходимо отличать ЗКО от метастазов рака молочной железы, меланомы кожи, неврилеммомы. Необходимо исключить малакоплакию, онкоцитарный карциноид и онкоцитому. Дифференцировку проводят с новообразованиями мягких тканей: дерматофибромой, лейомиомой. Диагностические сложности возникают при сочетании опухоли Абрикосова с другими новообразованиями, в частности с герминогенным раком яичка, лимфомой Ходжкина, раком бронхов.

Лечение опухоли Абрикосова
По возможности всем пациентам проводится оперативное удаление новообразования. При отсутствии явных признаков озлокачествления выполняется щадящий вариант операции с иссечением в пределах здоровых тканей. При локализации опухоли в стенке пищеварительного или дыхательного тракта применяют эндоскопические методы удаления, которые имеют лучший функциональный результат и короткий реабилитационный период.
Вероятность развития рецидивов в течение 4-х лет после проведения операции составляет 9-15%. Максимальному риску подвергаются люди, у которых проводилась экономная резекция тканей с сохранением части опухолевых клеток по краям операционного поля. При множественных очагах ЗКО Абрикосова проводятся внутриочаговые инъекции глюкокортикостероидов. Применение химиотерапии и лучевой терапии неэффективно, поэтому лечение злокачественных форм пока отсутствует.
При доброкачественных зернисто-клеточных опухолях продолжительность и качество жизни пациентов существенно не страдают, хотя возможны нарушения дыхания и пищеварения при соответствующих локализациях новообразования. Злокачественная форма ЗКО Абрикосова имеет крайне неблагоприятный прогноз, уровень 5-летней выживаемости составляет 35%. Профилактика заболевания не разработана ввиду отсутствия четких этиологических факторов.
1. Эндоскопическое лечение зернисто-клеточной опухоли пищевода (клинический случай)/ А.М. Гасанов// Доказательная гастроэнтерология. – 2020. – №3.
3. Зернисто-клеточная опухоль дыхательных путей/ И.В. Двораковская, Б.М. Ариэль, А.Н. Орлов, Л.В. Качан// Архив патологии. – 2013. – №3.
4. Наблюдение опухоли Абрикосова у ребенка/ В.К. Литовка, И.П. Журило, К.В. Латышов// Здоровье ребенка. – 2007. – №4.
Почечно-клеточный рак
Почечно-клеточный рак – это злокачественная опухоль, происходящая из эпителия, выстилающего почечные канальцы. Клиника включает общие симптомы (недомогание, похудание, субфебрилитет), местные проявления (макрогематурию, боли, пальпируемое образование) и признаки метастазирования. Диагностика базируется на данных экскреторной рентгенографии, селективной почечной ангиографии, УЗИ, КТ и МРТ, биопсию почки. Лечение определяется стадией неоплазии, может применяться нефрэктомия, лучевая терапия, химиотерапия, иммунотерапия и т. д.
Почечно-клеточный рак составляет 3% случаев от всех урологических новообразований. По распространенности рак почки стоит на третьем месте после рака простаты и мочевого пузыря, а по количеству летальных исходов занимает среди них первое место. В последние годы наметилась тенденция к умеренному росту заболевания. Мужчины страдают в 2-3 раза чаще, чем женщины. Раннее выявление и лечение рака почки является крайне актуальной проблемой современной урологии. На момент диагностики у 25-30% пациентов уже имеются отдаленные метастазы, еще у четверти определяется местно-распространенный процесс. Даже после радикальной нефрэктомии в ближайшие годы метастазы возникают в 40-50% наблюдений.
Несмотря на распространенность онкопатологии почек, о причинах почечно-клеточного рака можно говорить только предположительно. Одним из наиболее значимых этиологических факторов служит курение, вдвое повышающее вероятность развития патологии: с 30% у некурящих до 60% у курильщиков. Считается, что образование опухоли может быть связано с некоторыми профессиональными вредностями – контактом с нитрозосоединениями, асбестом, ядохимикатами, производными нефти, циклическими углеводородами, солями тяжелых металлов, ионизирующей радиацией. Прослеживается взаимосвязь между почечно-клеточным раком и злоупотреблением фенацетинсодержащими анальгетиками.
Многие исследования подтверждают роль ожирения и артериальной гипертензии в развитии рака почки. К факторам риска относят нефросклероз и приводящие к нему заболевания (нефролитиаз, сахарный диабет, хронический пиелонефрит, туберкулез, хроническая почечная недостаточность и др.). Принято считать, что неоплазия чаще развивается в аномально развитых почках – подковообразной, дистопированной, поликистозной и. д. Возникновение новообразования может быть генетически обусловленным транслокацией 3 и 11 хромосом.
В гистологической классификации различают несколько разновидностей рака в зависимости от встречающихся клеточных типов: светлоклеточный, железистый (аденокарциному), зернисто-клеточный, саркомоподобный (полиморфно-клеточный и веретеноклеточный), смешанно-клеточный. Макроскопическими признаками неоплазии служат сферическая форма опухоли, расположение в корковом слое почке, отсутствие истинной капсулы, периферический рост, многочисленные кровоизлияния, некрозы, кальцификаты, фиброзные участки.
Клинически важное значение имеет стадирование почечно-клеточного рака в соответствии с TNM-классификацией, где буквой Т обозначают первичную опухоль (tumor), N - регионарные лимфоузлы (nodulus), М - отдаленные метастазы (methastases):
- Т1 - новообразование наибольшим размером до 7 см, ограниченное почкой и почечной капсулой
- Т2 - новообразование свыше 7 см, ограниченное почкой и почечной капсулой
- Т3 - новообразование любого размера, прорастающее в околопочечную клетчатку либо распространяющееся в почечную или нижнюю полую вену
- Т4 – новообразование, прорастающее в околопочечную фасцию или соседние органы.
В I-II стадиях (T1-T2) поражение лимфоузлов и отдаленные метастазы отсутствуют (N0 М0). При III стадии раковые клетки выявляются в близлежащем лимфоузле. IV стадия почечно-клеточного рака может характеризоваться любым значением Т при наличии пораженных лимфоузлов либо отдаленных метастазов (N1 или М1). TNM-классификация позволяет определиться с лечебной тактикой и прогнозом.
Инвазивное новообразование может сдавливать или прорастать в желудок, поджелудочную железу, печень, кишечник, селезенку. Почечно-клеточный рак может метастазировать по гематогенному механизму (в другую почку, надпочечники, печень, легкие, кости, череп, головной мозг) и лимфогенному пути (в аортокавальные, парааортальные, паракавальные лимфоузлы, средостение). Характерно распространение в виде опухолевого тромба по венозным магистралям вплоть до правого предсердия.
Симптомы почечно-клеточного рака
Клинические признаки характеризуются классической триадой: гематурией, болью и пальпируемым новообразованием. Гематурия может быть микро- и макроскопической. Чаще на фоне удовлетворительного в целом состояния развивается внезапная тотальная, безболезненная гематурия, которая, как правило, отмечается однократно или продолжается несколько суток, а затем неожиданно прекращается. Если гематурия сопровождается отхождением бесформенных или червеобразных кровяных сгустков, может возникнуть обтурация мочеточника с развитием болевого приступа, напоминающего почечную колику. Повторные эпизоды гематурии могут наблюдаться через несколько суток или месяцев.
Характер болевых ощущений при почечно-клеточном раке зависит от происходящих изменений. Острые приступообразные боли возникают вследствие окклюзии мочеточника сгустком крови, кровоизлияния в ткань опухоли или инфаркта почки. Постоянные ноющие тупые боли могут вызываться сдавлением лоханки опухолью, прорастанием почечной капсулы, паранефрия и фасции Героты, прилежащих мышц и органов, вторичным нефроптозом. Боль может иррадиировать в половые органы и бедро, имитируя невралгию седалищного нерва.
Пальпируемая опухоль может определяться со стороны живота или поясницы в виде плотного или эластичного бугристого либо гладкого образования. Данный признак выявляется на поздних стадиях рака почки. Довольно рано появляются экстраренальные симптомы – артериальная гипертензия, лихорадка, интоксикация, похудение, анорексия, миалгия, артралгия, диспепсия и др. Из местных симптомов у мужчин часто встречается варикоцеле, вызванное сдавлением или тромбозом НПВ, яичковой или почечной вены.
Рак почки диагностируется по результатам жалоб, объективного осмотра, лабораторного, эндоскопического, ультразвукового, рентгеновского, томографического, радиоизотопного обследования, морфологического исследования биоптата тканей опухоли и метастатических лимфоузлов. В крови отмечается эритроцитоз, анемия, ускорение СОЭ, гиперурикемия, гиперкальциемия, синдром Штауффера. Цистоскопия, проведенная в момент гематурии, позволяет выяснить источник кровотечения и сторону локализации опухоли.
УЗИ почек является первым инструментальным обследованием при подозрении на почечно-клеточный рак. Характерными эхографическими признаками служат увеличение размеров почки, неровность контуров, изменение эхоструктуры, деформация почечных синусов и чашечно-лоханочных комплексов. УЗДГ сосудов почек позволяет определить характер васкуляризации опухоли и вовлеченность сосудов.
Экскреторная урография позволяет судить лишь о косвенных признаках рака почки, однако дает ценную информацию о сопутствующих изменениях (аномалиях, камнях почки, гидронефрозе, состоянии противоположной почки). Почечная ангиография проводится с целью визуализации опухолевых тромбов. МРТ и КТ почек используются как альтернатива экскреторной урографии и почечной ангиографии. С помощью томографии удается получить точное представление о стадии неоплазии и определиться с лечебной тактикой. Радиоизотопная нефросцинтиграфия и позитронно-эмиссионная томография помогают оценить функционирование здоровой и пораженной почки.
Дифференциальная диагностика проводится с нефроптозом, гидронефрозом, поликистозом почек, пионефрозом, абсцессом и т. д. Решающее значение в сомнительных ситуациях принадлежит биопсии почки и морфологическому исследованию биоптата. Выявление метастазов в отдаленных органах возможно с помощью рентгенографии грудной клетки, костей, УЗИ брюшной полости.
Лечение почечно-клеточного рака
Единственным радикальным методом лечения патологии является нефрэктомия. Простая нефрэктомия включает удаление почки и паранефральной клетчатки; радикальная нефрэктомия подразумевает дополнительное удаление надпочечника и фасций, паракавальную и парааортальную лимфаденэктомию; расширенная нефрэктомия – резекцию других пораженных органов. Нефрэктомия при почечно-клеточном раке выполняется трансперитонеальным, торако-абдоминальным или лапароскопическим доступом.
При метастазировании новообразования в кости скелета может проводиться ампутация, экзартикуляция конечности, резекция ребер и т. д. Доступные иссечению метастазы в печени, легких, лимфоузлах также подлежат хирургическому удалению. В дополнение к радикальной нефрэктомии, а также при неоперабельном почечно-клеточном раке и его рецидивах целесообразно проведение лучевой терапии, гормонотерапии, химиотерапии, иммунохимиотерапии, общей гипертермии.
Важным критерием отдаленного прогноза служит распространенность почечно-клеточного рака. Современные данные свидетельствуют, что при радикальном удалении рака почки I стадии 5-летняя выживаемость близка к 70-80%, II стадии – к 50-70%, III стадии — к 50%, IV стадии — менее 10%. Диспансерное наблюдение и контрольное обследование пациентов проводится врачом-нефрологом. Профилактика предусматривает исключение факторов риска, повышающих вероятность образования неоплазии.
Зернистоклеточная опухоль. Признаки и диагностика зернистоклеточной опухоли.
Зернистоклеточная опухоль (син.: зернистоклеточная миобластома, опухоль Абрикосова, зернистоклеточная неврома, зернистоклеточная нейрофиброма, миоэпителиальная опухоль, зернистоклеточная периневральная фибробластома, миобластная миома, зернистоклеточная рабдомиобластома, зернистоклеточная шваннома) — редкая доброкачественная опухоль, впервые выделенная в 1925 г. А.И. Абрикосовым, который на основании случаев развития опухоли в поперечнополосатых мышцах языка и сходства опухолевых клеток с эмбриональными миобластами предположил, что она имеет мышечное происхождение.
Мышечное происхождение зернистых клеток опухоли подтверждали и ранние исследования тканевых культур. В дальнейшем появился ряд работ, в которых на основании результатов ферментных окрашиваний была высказана гипотеза, что зернистые клетки опухоли скорее всего берут свое начало из оболочки нерва, а не из мышц. Так, J.C. Garancis (1970) предположил, что зернистые клетки представляют собой разновидность шванновских клеток с лизосомальным дефектом, в которых остаточные тельца вторичных лизосом накапливают неполностью распавшийся гликоген. Происхождение опухоли из шванновских клеток было подтверждено и другими авторами, обнаружившими в клетках опухолей протеин S-100 и миелин с помощью иммунопероксидазных методик: экспрессию протеина основного миелина и других протеинов миелиновых волокон периферических нервов; мышечные же белки, напротив, при этом выявлялись не всегда. Была описана также положительная реакция цитоплазматических гранул зернистоклеточных опухолей на антитела к лизосомальному гликопротеину CD68, используемому в качестве маркера макрофагов. Поэтому высказывалась точка зрения об их связи с недифференцированной мезенхимой, о гистиоцитарном происхождении опухоли. Однако экспрессия лизосомального гликопротеина CD68 (КР-1) при обеих разновидностях зернистоклеточных опухолей и шванномах подтверждала концепцию их общего гистогенеза.
В последние годы были опубликованы данные ультраструктурных и иммуногистохимических исследований зернистоклеточной опухоли, свидетельствующие о происхождения опухоли Абрикосова из клеток Лангерганса. Эти клетки обнаружены в большинстве эпителиальных тканей и имеют нейроэктодермальное происхождение, которое подтверждается экспрессией протеина S-100. Зернистоклеточная опухоль встречается преимущественно на 4-6-м десятилетиях жизни (средний возраст больных 39 лет). В ряде случаев ее описывают у детей и лиц пожилого возраста. Женщины поражаются в 3 раза чаще, чем мужчины. Семейные случаи редки. От 33 до 44% зернистоклеточных опухолей появляется в коже и подкожной клетчатке. Другой частой локализацией (23-35% случаев) является язык, реже поражаются другие отделы полости рта: губы, слизистая оболочка щек, нёбо, дно ротовой полости изредка опухоль развивается в гортани, трахее, бронхах, пищеводе, желудке, желчевыводящих путях, толстой кишке, прямой кишке, молочной железе, слюнных железах, мышцах передней брюшной стенки, мочевом пузыре. У 42,7% больных с множественными опухолями наблюдается сочетанное поражение кожи и внутренних органов.

Зернистоклеточная опухоль
Клинически зернистоклеточная опухоль не имеет характерных особенностей. Обычно она солитарная, множественные опухоли отмечаются в 4-30% случаев. Представляет собой хорошо отграниченный, плотный дермальный или подкожный узел диаметром от 0,5 до 6,5 см с гладкой поверхностью. Изредка опухоль может быть на ножке, иметь гиперпигментированную, бородавчатую, гиперкератотическую или изъязвленную поверхность. Опухоль, как правило, бессимптомна и лишь иногда сопровождается зудом или парестезиями.
Течение зернистоклеточной опухоли медленное. Озлокачествление наблюдается крайне редко, однако описаны злокачественные зернистоклеточные опухоли с метастазами в лимфатические узлы и внутренние органы.
На срезе большинство зернистоклеточных опухолей имеет серую, белую или желтую окраску, слегка зернистую поверхность с легкой узловатостью и нечеткими сероватыми прослойками. Хотя макроскопически доброкачественные зернистоклеточные опухоли хорошо очерчены, до 50% из них инфильтрируют окружающую жировую клетчатку или мышцы.

Зернистоклеточная опухоль:
а - у 4-летнего мальчика очаги на губах
б - у него же на слизистой щек были замечены при рождении.
Гистологическое строение зернистоклеточной опухоли.
Гистологически доброкачественные зернистоклеточные опухоли состоят из крупных полигональных или веретенообразных клеток с яркой зернистой цитоплазмой и одинаковыми центрально расположенными круглыми или овальными слегка вакуолизированными ядрами. Клетки группируются в гнезда или тяжи, разделенные тонкими фиброзными перегородками.
Характерным признаком доброкачественных зернистых опухолей кожи и слизистых оболочек, в частности языка, является выраженная псевдоэпителиоматозная гиперплазия покровного многослойного плоского эпителия, которая может вызвать тревогу у неопытного морфолога и привести к неправильному диагнозу плоскоклеточного рака, особенно при поверхностной биопсии.
Цитоплазма полигональных клеток зернистоклеточной опухоли светлая, оксифильная, содержит мелкие, эозинофильные ШИК-положительные гранулы до 5 мм в диаметре. Эти гранулы могут быть окружены зоной просветления. По соседству с сосудами располагаются клетки меньших размеров и вытянутой формы, напоминающие фибробласты, но также содержащие крупные ШИК-положительные частицы (angulated bodies). Эти клетки описываются также как интерстициальные клетки или сателлитные фибробласты. В тесной связи с зернистыми клетками можно видеть и мелкие нервные волокна. В строме опухоли отмечаются скопления лимфоцитов плазмоцитов, небольшое количество тонкостенных сосудов, по периферии — выраженный инфильтратив-ный рост.

При ультраструктурном исследовании в опухоли Абрикосова также обнаруживается два типа клеток. Обычно преобладают крупные полигональные клетки с многочисленными, различными по протяженности извитыми цитоплазматическими отростками. Ядра клеток также имеют полигональную форму с глубокими инвагинациями, хроматин мелкозернистый, равномерно распределен в кариоплазме, ядрышки встречаются редко. Межклеточные границы обычно прослеживаются с трудом, что связано со сложным переплетением цитоплазматических отростков лежащих рядом клеток. Соседние клетки контактируют между собой. Межклеточные контакты имеют вид слипаний, десмосомы не обнаруживаются. В телах клеток и варикозных расширениях клеточных отростков определяются многочисленные митохондрии, элементы эндоплазматического ретикулума и осмиефильные гранулы, количество которых может варьировать в зависимости от количества органелл клетки могут быть светлыми и темными. Второй тип клеток меньше по размеру, вытянутой формы, с немногочисленными тонкими, длинными отростками, простирающимися на значительное расстояние между телами полигональных клеток, но не контактирующими с последними. Ядра вытянутой овальной формы, ядерный хроматин мелкозернистый, с тенденцией к маргинальным скоплениям, часто встречаются гипертрофированные ядрышки. В цитоплазме клеток содержится различное количество осмиефильных гранул, расширенные цистерны шероховатого эндоплазматического ретикулума с рыхлой микрогранулярной субстанцией, увеличенное количество полиморфных митохондрий, гранулы гликогена.
Характерным ультраструктурным признаком клеток зернистоклеточной опухоли являются специальные цитоплазматические тельца, которые и придают им на светооптическом уровне зернистый вид. По размеру и организации можно выделить 3 типа телец. Тельца I типа (гранулы Бирбека) длиной 0,6 мкм и шириной 0,04-0,05 мкм имеют своеобразную форму, напоминающую теннисную ракетку. В центре этих телец содержится электронно-плотный стержень, окруженный зоной просветления, окаймленной мембраной. Одни участки стержня представлены сгруппированными микротрубочками, другие более однородны из-за накопления электронно-плотной осмиефильной субстанции. У одного из полюсов тельца определяется колбовидное расширение, содержащее микрогранулярную субстанцию слабой электронной плотности. Тельца I типа обнаруживаются, как правило, в периферической зоне цитоплазмы светлых полигональных клеток с развитым аппаратом Гольджи.
Тельца II типа зернистоклеточной опухоли представляют собой осмиефильные гранулы неправильных очертаний. диаметром до 3 мкм. Гранулы обычно тесно связаны с шероховатым и гладким эндоплаз-матическим ретикулумом, они окружены двухслойной мембраной, которая может переходить в мембрану эндоплазматического ретикулума. Тельца II типа имеют тенденцию к слиянию и вместе с окружающими их цистернами ретикулума и концентрическими мембранными структурами нередко сливаются в крупные осмиефильные тела с неоднородным содержимым, напоминающие фаголизосомы.
Цитоплазматические тельца III типа зернистоклеточной опухоли самые крупные, они имеют округло-овальные очертания, окружены непостоянной двухконтурной мембраной и содержат микротрубочки, структура которых отчетливо видна на поперечных срезах, и небольшие скопления микрогранулярной субстанции. Некрупные тельца III типа сходны по своей структурной организации с премеланосомами 2-го порядка.
Приведенные ультраструктурные данные свидетельствуют, что зернистоклеточная опухоль представлена клетками неэпителиальной природы. Признаки миогенной дифференцировки отсутствуют. Имеется некоторое сходство с клетками оболочек периферических нервов, но в целом опухоль отличается от нейрофибром наличием двух типов клеток и специфических гранул в цитоплазме. Особого вмимания требует обнаружение в опухолевых клетках гранул, по форме напоминающих теннисную ракетку. Подобные гранулы были впервые описаны М. Birbeck и соавт. в 1961 г. в клетках Лангерганса. Клетки Лангерганса бывают двух типов: светлые и темные. И те, и другие содержат гранулы Бирбека, но светлые клетки в значительно большем количестве. Светлые клетки располагаются среди шиповатых в супрабазальных слоях эпидермиса и имеют большое количество цитоплазматических отростков. Темные клетки иногда принимают за меланоциты, их немногочисленные тонкие отростки простираются на значительное расстояние между кератиноцитами. Кроме гранул Бирбека в цитоплазме клеток Лангерганса обнаруживаются многочисленные осмиефильные гранулы с высокой электронной плотностью и своеобразные структуры из компактно расположенных микротрубочек диаметром 120-200 нм.
Диагноз опухоли Абрикосова устанавливается на основании результатов гистологического исследования.
Дифференциальный диагноз доброкачественной зернистоклеточной опухоли проводится со злокачественной зернистоклеточной опухолью, эпидермальной кистой с включениями, волосяной кистой, липомой, пиломатриксомой, гиберномой, нейрофибромой, множественной стеатокистомой и метастазами злокачественных новообразований внутренних органов в кожу. При наличии болезненности и чувствительности следует исключать лейомиому, эккринную спираденому, неврому, дерматофиброму, ангиолипому, неврилеммому, эндометриому и гломусную опухоль.
Лечение зернистоклеточной опухоли заключается в хирургическом удалении опухоли в широких пределах. Рецидивы встречаются с частотой от 9 до 15% и обусловлены сохранением Б операционном крае опухолевых клеток, однако только 21% больных с наличием клеток опухоли в крае резекции имели рецидивы через 4 года. Внутриочаговые инъекции кортикостероидов приводят только к частичному регрессу множественных опухолей. Лучевая терапия также неэффективна. Изредка доброкачественные зернистоклеточные опухоли регрессируют спонтанно (частично или полностью) без рубцевания. При крупных опухолях требуется длительное наблюдение, так как метастазы отмечаются даже при зернистоклеточных опухолях, выглядящих гистологически доброкачественными.

Зернистоклеточная опухоль:
а - бессимптомные папулы и узлы развились на кончике языка у этого малыша
б - на дорсально-латеральной поверхности языка у подростка
Читайте также:
